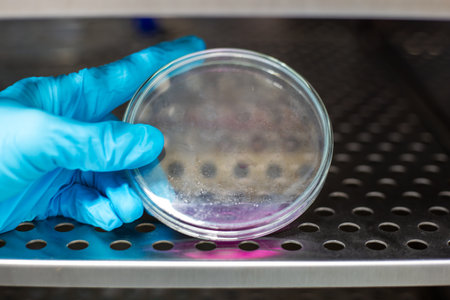
Close-up of a scientist wearing blue gloves holding a Petri dish with pink solution inside a laboratory incubator for microbiology research.の写真素材

写真素材 - Close-up of a scientist wearing blue gloves holding a Petri dish with pink solution inside a laboratory incubator for microbiology research.
作品情報
Close-up of a scientist wearing blue gloves holding a Petri dish with pink solution inside a laboratory incubator for microbiology research.
- ID:257212649
- 作品種別:写真
- 作者名:Suriphon Singha
キーワード
- analysis
- bacteria
- bio lab
- biochemistry
- biology
- biotechnologist
- biotechnology
- blue gloves
- cell culture
- chemical
- chemistry
- clinical
- close-up
- culture
- culture dish
- discovery
- equipment
- experiment
- gloves
- hand
- healthcare
- healthcare professional
- incubator
- innovation
- investigation
- lab
- lab incubator
- laboratory
- laboratory work
- liquid
- medical
- medicine
- microbiologist
- microbiology
- organism
- petri
- petri dish
- pink liquid
- pink solution
- research
- research lab
- science
- science concept
- scientific
- scientific experiment
- scientist
- sterile
- sterile environment
- study
- technology
- test
類似作品
Portrait of an ...
A scientist wit...
young 8 yo boy ...
A scientist in ...
Innovative Fema...
A confident sci...
Young woman sci...
laboratory assi...
Medical theme: ...
Doctor making h...
A scientist in ...
Portrait of boy...
Portrait of a b...
A senior doctor...
A female techni...
preventing viru...
portrait of a m...
African-America...
Expert Examinin...
Animal wearing ...
A woman in a pr...
Professional fe...
Elderly Man Wit...
Chemist holding...
An engineer hol...
Close-up portra...
An elderly scie...
Portrait of a c...
An elderly scie...
Asian doctor or...
Senior Scientis...
Male Doctor Wea...
A scientist wit...
Medical error. ...
Child joyfully ...
A healthcare wo...
Virologist is w...
Science and edu...
A man wearing a...
Mature woman in...
Young woman ove...
Boy engaged in ...
Tiredness - you...
doctor in prote...
A man in lab co...
Doctor working ...
Confident Femal...
Laboratory tech...
doctor or scien...